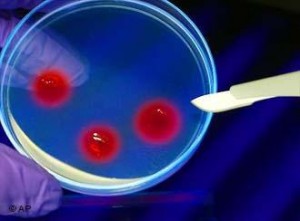

Una sola dosis del pequeño ácido ribonucleico de interferencia (siRNA) fármaco candidato de ALN-PCS para cortar los niveles de colesterol LDL (colesterol malo) en voluntarios sanos hasta en un 57% y 40%, en promedio, más de los que recibieron un placebo, según el Un nuevo estudio publicado en The Lancet.
«Estos resultados de fase I allanar el camino para la terapéutica del ARN de interferencia ( RNAi ) como un posible tratamiento para el colesterol alto » , explica el juicio investigador Kevin Fitzgerald de Alnylam Farmacéuticos que ayudó a desarrollar el nuevo siRNA.
«Estos resultados de fase I allanar el camino para la terapéutica del ARN de interferencia ( RNAi ) como un posible tratamiento para el colesterol alto » , explica el juicio investigador Kevin Fitzgerald de Alnylam Farmacéuticos que ayudó a desarrollar el nuevo siRNA.
«Si se desarrolla con éxito, este tipo de medicamentos podría ser una alternativa para uno de cada cinco personas que son resistentes a las estatinas, o se combinan con estatinas para producir aún mayores efectos para los muchos otros para los que el tratamiento de primera línea actual no bajar el colesterol suficiente» .
ALN -PCS funciona bloqueando la producción del regulador de colesterol PCSK9 ( proproteína convertasa subtilisina / kexina tipo 9 ) – una proteína que destruye las lipoproteínas de baja densidad ( LDL) que normalmente es transparente el colesterol LDL de la sangre.
Los estudios genéticos han demostrado que las mutaciones que resultan en un aumento de la concentración de PCSK9 o actividad de plomo a un importante aumento en el colesterol LDL que contribuye a la acumulación de placa dentro de los vasos sanguíneos, mientras que las mutaciones que causa el colesterol menos PCSK9 menor actividad drásticamente. Lo que es más, la evidencia sugiere que las estatinas aumentan la producción de PCSK9, lo que podría limitar su eficacia.
Sobre la base de una serie de estudios preclínicos con éxito , los investigadores de los EE.UU. y el Reino Unido reclutaron 32 voluntarios sanos, de 18 a 65 años, con niveles moderadamente el colesterol LDL moderadamente elevada. Los voluntarios fueron asignados al azar para recibir una de las seis dosis intravenosas de ALN- PCS , o placebo (solución salina normal).
ALN- PCS fue generalmente bien tolerado , con una proporción similar de los voluntarios en dos grupos que sufren de leves a moderados efectos adversos ( 79 % vs 88 %). Los investigadores observaron cambios clínicamente significativos en los marcadores de la función hepática o inflamación.
Infusión de ALN- PCS llevó a una rápida reducción dependiente de la dosis en el plasma PCSK9 , con dosis más altas tienen efectos más duraderos . Para los que recibieron la dosis más alta de la ALN- PCS ( 0.400mg/kg ) , los niveles plasmáticos PCSK9 cayeron hasta un 84 % (promedio 70 % ) , y el colesterol LDL se redujo hasta en un 57 % (promedio 40 % ) , en comparación con placebo.
De acuerdo con Fitzgerald , » Esta es la primera vez que el efecto de un fármaco candidato ARNi ha sido demostrado en un punto final clínicamente validado ( colesterol LDL ) , así como la realización de las estatinas que proporcionan aproximadamente el 36 % a 53 % gotas en el colesterol LDL . La siguiente paso será el estudio de dosis múltiples más grandes sin el uso de premedicación para hacer frente a la seguridad a largo plazo y la tolerabilidad de la ALN- PCS en diversas poblaciones de pacientes , incluyendo los de las estatinas y los que están con estatinas intolerantes » .
Comentando sobre el estudio, John R Burnett y Amanda J Hooper de la Universidad de Australia Occidental dicen , » la inhibición PCSK9 se perfila para ser un medio eficaz para reducir el colesterol LDL en pacientes con hipercolesterolemia severa o refractaria que no son capaces de tolerar las estatinas o no han alcanzado concentraciones objetivo de colesterol LDL . Dado que las estatinas regulan al alza PCSK9 , limitando potencialmente su eficacia , el tratamiento de combinación con la adición de un inhibidor de PCSK9 podría mejorar el efecto reductor de LDL de las estatinas solas . «
colesrerol pcs, cambogia estatinas, como funciona el PCSK9






